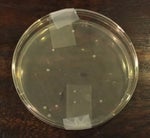
skyler

00:0000:44
1.6K
- 165

Clash of clans Little prince edit
MeterMajorLow30576
- 733

vengeance of she
zalq
- 283

Untitled video Made with Clipchamp
OpticalScaleFormant161
- 598
skyler
GatedTriangleOverdrive17818
- 499

Papin Olimpos Oficiantka 66221705
TapeMeterIntensive63437
- 1.1K

ambatukaAMAMAMM
ilovewomen
- 344

caloocan spotted multiverse
juliusdale23
- 361

Vice Guaraldi Trio -Moon River 3
CondenserSpectrumBuffer20664
- 433

Vince Guaraldi Trio - Moon River
CondenserSpectrumBuffer20664
- 1.6K

hidden past kevin macleod
KingOfGames
- 1.4K

Clash Royale Gameplay No Commentary 1
AnalogReflectionChorus5567
- 3.3K

Clash of Clans Intro QuickSounds
v45Darkside2


